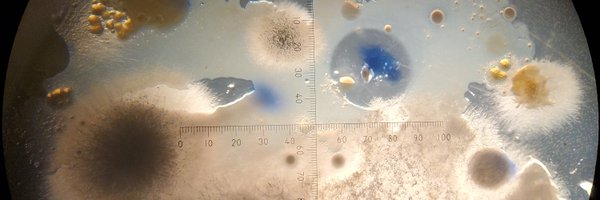
DMW_Microbiome Profile Banner

Donny M. Walker, PhD
@DMW_Microbiome
Followers
536
Following
2K
Media
17
Statuses
523
Mycologist. Microbial ecologist. PI of Microbiome ecology lab at Middle Tennessee State University. Assistant Professor of Microbiology
Murfreesboro, Tennessee
Joined September 2021
Our first outreach video! Check out our herptile gut microbiome work with @hyphaltip @zygolife @SpataforaJoey
https://t.co/f7o7rL2aXz
1
8
19
We are happy to anounce the start of the new IUCN SSC Aquatic Fungi Specialist Group. We aim at working towards #aquaticfungi conservation. Incl. #freshwater and #marine. Stay tuned ! 🍄💧 @IUCN @IUCNssc @IUCNfungi @SSCmarine @FW_Conservation
2
10
33
#ICYMI Congrats to Liz Barnes & Donny Walker! @mtsu_biology @MTSUBiologyClub @NSF
#grants #mtsusciences @lizard_barnacle
@DMW_Microbiome Road to success: two MTSU faculty journey from 1st-generation students to award-winning scientists https://t.co/l864o5BYeb via @MTSUNews
0
6
12
Faculty Job in my department - Assistant Professor in Fungal Biology - UC Riverside
2
132
154
Another of my favourite sequences from the upcoming movie, Fungi: Web of Life. Björk explains how fungi are able to digest wood. The incredible time lapse footage is by Steve Axford (Planet Fungi). Link in my bio for more info.
27
565
2K
We have an open postdoc and a doctoral student position to work on molecular mechanism underlying arbuscular mycorrhiza symbiosis. Expertise on protein biochemistry is a plus. Please apply here:
umantis.com
► Gestalten statt verwalten! Professionalisieren Sie Ihre HR-Arbeit mit unserer modularen und komplett integrierten Umantis HR-Suite.
4
218
271
My department is searching for a Postdoc Fellow that will convert to a tenure-track Asst Professor job after 1-2 years! Do you use eDNA? Or remote sensing? Or modeling? Or field work? Do you study environmental science? Or paleoclimate? Or #BEAVERS? Our search is broad! Apply!
9
282
399
Come work here as a post doc in STEM Ed research! @GrantGardner19 will be an excellent guide during your post doc and we have dozens of math and science education professors here at MTSU that guides a healthy and vibrant STEM Ed community.
The Department of Biology @MTSU invites applications for a 12-month, full-time Postdoctoral Research Fellow in STEM Education Research beginning as early as January 1, 2024. @CbasMtsu @GrantGardner19
https://t.co/ddTVp7RsLl
https://t.co/QaiXb8X0HE
0
8
8
Come work with me! I can attest that MTSU biology department is one of the good places to land in academia.
The Department of Biology @MTSU invites applicants for a full-time, tenure-track faculty position in Forensic Science at the rank of assistant or associate professor. The start date for the position is August 1, 2024. @CbasMtsu #MTSUsciences
https://t.co/TL0WlNXkQt
0
6
14
Our vacancy for an Assistant Professor in Plant-Microbe Interactions is still open until 2 October. We especially welcome topics that we do not cover already ourselves. Interested? Apply here:
academictransfer.com
Are you passionate about discovering conceptually novel principles in plant-microbe interactions? Then apply to become our new team member!
1
75
85
This is how I advise my #PhD students to write research manuscripts (in case someone finds it helpful). General points: 1. Research questions addressed by your manuscript are key and should guide you. 2. Don’t view your manuscript as an article. See it as a STORY. 3. Pick the
65
1K
6K
Follow biologist Verónica Toledo in her pursuit Darwin's frog, an evolutionary marvel that persists only in scattered pockets of southern Chile. Watch the Third-Place Winner in the 2023 @YaleE360 Film Contest: https://t.co/nzSm304A55
1
5
17
Tiny urban forests can help #rewild urban settings and help fight #climatechange. The brainchild of the Japanese botanist Miyawaki is taking his idea global. We have so many solutions. Implement them. #ActOnClimate
#climate #forests #nature #biodiversity
104
2K
3K
Also, an early heads up that I’ll be advertising a bioinformatics PhD position on phage defence (what else?!) in the coming weeks.
Interested in joining our lab at Lund University @lunduniversity to study new antiphage defence systems? Experiment (us) + bioinformatics (@gem__atkinson )! Wenner-Gren fellowship deadline is October 1st. DM me if interested. RT is appreciated.
0
25
46
Integrated Human Skin Bacteria Genome Catalog Reveals Extensive Unexplored Habitat‐Specific Microbiome Diversity and Function - Li - Advanced Science - Wiley Online Library
advanced.onlinelibrary.wiley.com
Researchers recover 2111 high-quality genomes and 3668 medium-quality from 2519 human skin metagenomes, clustering yields 813 prokaryotic species including 470 novel species. Genomic analyses reveal...
0
13
38
I will soon open several post doc positions in my @ERC_Research Advanced grant. If you're at @icpp2023 and are interested in working on the ecology and evolution of natural plant-microbe communities both above- and below-ground, please reach out. I would be happy to chat more!
9
110
160
Faculty, Students, & Staff invited! Research & Sponsored Programs Raider Research Series Hear #mtsuchemistry profs Dr. Keying Ding & Dr. Kevin Bicker Fri, Sept 8 3-4pm MT Ctr, Ingram Bldg (corner of Lytle & MT Blvd) #mtsusciences @TheBickerLab RSVP: https://t.co/Ke4Zo7F5LA
0
3
3